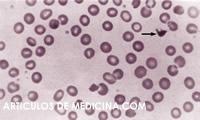

Anemia
-
Anemia se define la anemiacomo la disminución de la masa eritrocitaria. En la práctica clínica hablamos de anemia cuando se produce una disminución del volumen de hematíes medido en el hemograma mediante el número de hematíes, el hematocrito, y mejor aún, la concentración de hemoglobina.
En el enfermo anémico se produce un aumento del 2-3 DPG eritrocitario. Esta situación, al igual que la acidosis sanguínea o el aumento de temperatura, disminuye la afinidaddelahemoglobinapor el O2 (desplazamiento de la curva de saturación a la derecha).
Evaluación del enfermo con anemia
En el estudio del enfermo anémico, existen tres parámetros básicos que ayudan en el diagnóstico diferencial: el volumen corpuscular medio del hematíe, porcentaje de reticulocitos, y frotis de sangre periférica
VOLUMEN CORPUSCULAR MEDIO DEL HEMATÍE (VCM).
Según el tamaño del hematíe, las anemias se dividen en microcíticas (<80 micras cúbicas), normocíticas o macrocíticas (>100 micras cúbicas).
Anemias microcíticas
En general, las anemias microcíticas se suelen acompañar de hipocromía, ya que el tamaño del hematíe se encuentra reducido en aquellos casos en los que disminuye la cantidad de hemoglobina (cromía). Ya que la hemoglobina está constituida por una mezcla de hierro, cadenas de globina y pigmento hem, las enfermedades en las que se produce alteración de alguno de estos componentes, en general presentan un tamaño pequeño. La causa más frecuente de microcitosis es la ferropenia. La anemia de enfermedad crónica, a pesar de que habitualmente es normocítica, puede ser microcítica, al igual que las talasemias, las anemias sideroblásticas hereditarias y la intoxicación por plomo.
Anemias normocíticas
La causa más frecuente es la denominada anemia de enfermedad crónica o por mala utilización del hierro (esta anemia ocasionalmente puede ser microcítica).
Anemias macrocíticas
 La mayoría de las anemias macrocíticas son megaloblásticas. No se debe confundir el concepto de macrocitosis, tamaño grande del hematíe, con el de megaloblastosis, tamaño grande de precursores hematológicos en la médula ósea. Por supuesto, todas las anemias megaloblásticas son macrocíticas, pero no todas las anemias macrocíticas son de causa megaloblástica. Las anemias secundarias a tratamiento quimioterápico, la aplasia de médula ósea, el hipotiroidismo, la hepatopatía crónica, los síndromes mielodisplásicos y las anemias sideroblásticas adquiridas pueden tener un tamaño grande del hematíe. También la hemólisis o el sangrado agudo debido a la respuesta reticulocitaria puede simular un falso aumento del VCM, puesto que los reticulocitos son células de mayor tamaño que el hematíe y la máquina que los contabiliza no lo discrimina.
La mayoría de las anemias macrocíticas son megaloblásticas. No se debe confundir el concepto de macrocitosis, tamaño grande del hematíe, con el de megaloblastosis, tamaño grande de precursores hematológicos en la médula ósea. Por supuesto, todas las anemias megaloblásticas son macrocíticas, pero no todas las anemias macrocíticas son de causa megaloblástica. Las anemias secundarias a tratamiento quimioterápico, la aplasia de médula ósea, el hipotiroidismo, la hepatopatía crónica, los síndromes mielodisplásicos y las anemias sideroblásticas adquiridas pueden tener un tamaño grande del hematíe. También la hemólisis o el sangrado agudo debido a la respuesta reticulocitaria puede simular un falso aumento del VCM, puesto que los reticulocitos son células de mayor tamaño que el hematíe y la máquina que los contabiliza no lo discrimina.RECUERDA
- El alcoholismo es la causa más frecuente de macrocitosis sin anemia.
- La anemia megaloblástica por déficitdeácidofólicoeslacausa más frecuente de anemia macrocítica.
RETICULOCITOS
Los reticulocitos son hematíes jóvenes (ya sin núcleo). Su presencia en la sangre periférica traduce la función de la médula ósea. El porcentaje de reticulocitos en referencia al total de hematíes en sangre periférica es del 1% al 2%. Las anemias que presentan elevación en el número de reticulocitos reciben el nombre de anemias regenerativas, y el prototipo de dichas anemias es la hemólisis o el sangrado agudo. Las anemias que no elevan el número de reticulocitos en la sangre o lo presentan descendido reciben el nombre de anemias hiporregenerativas, y el prototipo es la aplasia medular. En general, un número no elevado de reticulocitos suele traducir una enfermedad de la propia médula ósea o bien un trastorno carencial, que impide que la médula ósea sea capaz de formar células sanguíneas. En este sentido, una excepción sería la invasión de la médula ósea por metástasis (anemia mieloptísica), en cuyo caso los reticulocitos pueden estar incrementados a pesar de presentar la médula ósea una enfermedad.
ESTUDIO DE LA EXTENSIÓN DE LA SANGRE PERIFÉRICA
Se trata del estudio de la morfología de las células sanguíneas, no solamente de la serie roja, sino del resto de las otras series.
Ejemplo de hallazgos en la extensión de sangre periférica y su correlación con algunas enfermedades:
- Dacriocitos o hematíes en lágrima - mieloptisis.
- Poiquilocitos (son variaciones en la forma del hematíe) - mielodisplasia.
- Dianocitos - hemoglobinopatías.
- Punteado basófiloprominente-intoxicaciónporplomooanemias sideroblásticas, talasemias-.
- Policromatófilos-hemólisis.
Esquistocitos
- Esferocitos - esferocitosis hereditaria o inmunohemólisis.
- Cuerpos de Heinz (se producen por desnaturalización de la hemoglobina) - hemólisis por oxidantes en deficienciadeglucosa6fosfatodeshidrogenasa o hemoglobinopatías y esplenectomizados.
- Esquistocitos o hematíes fragmentados - hemólisis traumática.
- Cuerpos de Howell-Jolly - hipoesplenismo.

August 17th, 2009 at 8:34 pm
Me parecen muy interesantes son d mucha ayuda para el catedratico de la hematologia en la parte del laboratrio
September 25th, 2009 at 12:43 pm
Es muy completa la informacion y nos es de mucha ayuda para complementar dudas que se nos presentan GRACIAS
July 31st, 2010 at 6:02 am
Estupendo artículo con sabios consejos sobre la Anemia. Para poder estar en contacto con personas que tienen La Anemia perniciosa les invitamos a visitar este foro http://www.lasenfermedades.com/foro/viewtopic.php?f=4&t=2
October 17th, 2010 at 7:43 pm
la informacion me es muy util y es muy buena me saco muchas dudas que tenia y esta muy interesante GRACIAS